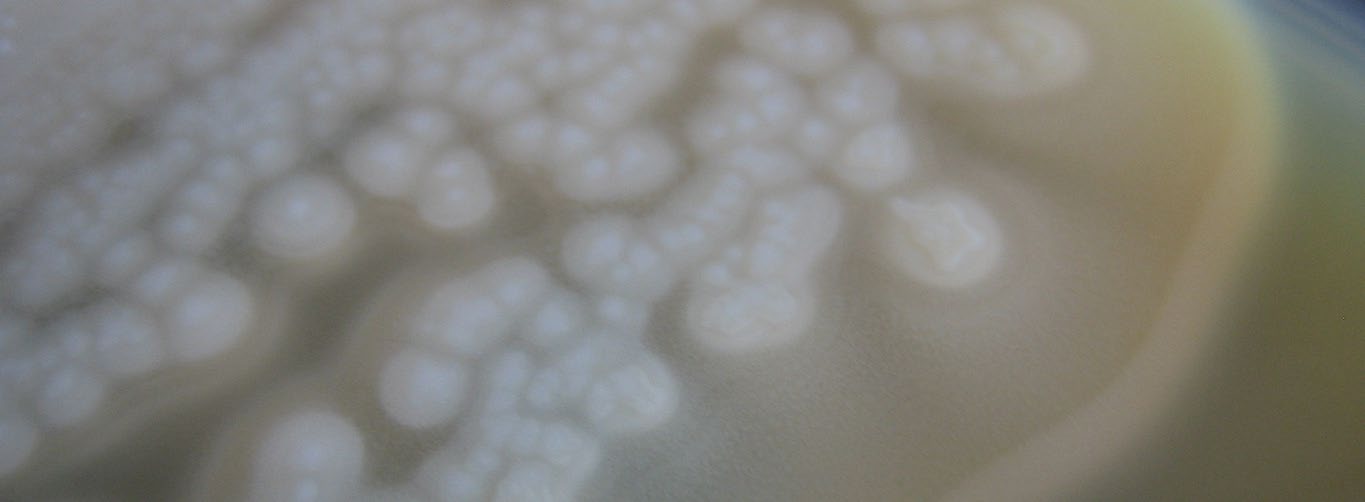

MSU Extension Supports Meat Processors in Assuring a Safe Food Supply
DOWNLOADJune 13, 2024 - Michigan State University Extension
- Over 300 additional retail or custom exempt facilities are in Michigan (USDA, 2024).
- $200 Pork Quality Assured farms receive in added value compared to selling from a noncertified farm.
- Over 1.2 million hogs a year are raised by Michigan pig farmers (MDARD, 2023).
- 184 USDA-inspected meat and poultry establishments are in Michigan; 154 are small or very small establishments (USDA, 2024).
Priority Areas
Michigan State University (MSU) Extension works to increase farmers’ success while protecting the environment, ensuring food safety, reaching new markets and advancing agriculture through applied research. Agriculture is now one of the fastest-growing sectors of the Michigan economy. MSU Extension serves the animal agriculture industry by engaging in research, education and outreach that enhances the quality of life for constituents throughout the state. MSU Extension’s agriculture literacy efforts strive to improve consumer knowledge and trust in animal care, food safety and modern food production methods.
Public Safety Ensured Through Quick Intervention by Processor and MSU Extension
MSU Extension assisted a Michigan meat processor with evaluating product modeling after the processor's chiller failed over a weekend and the product sat at temperatures above 50 degrees Fahrenheit for over 36 hours. Some lots of the product were tested to have little to no growth of pathogenic organisms. One lot of approximately 6,800 pounds (estimated 34,000 servings) of product was shown to have a slight amount of growth of Clostridium botulinum, a bacterium harmful to humans, as the product was held at too high of a temperature. MSU Extension evaluated the pathogen modeling outcomes and advised the food safety manager to input worst-case scenarios into the pathogen modeling. Ultimately, MSU Extension experts determined the product had to be destroyed to keep the public safe and not cause any foodborne illness, including the life-threatening severity that Clostridium botulinum could cause.
"Thank you for helping us. Today, we are saving lives by not putting this product into commerce!" -Michigan business owner
MSU Provides Accessible Pork Quality Assurance Course for Over 100 Amish Smith-Holder Pork Producers

Pork Quality Assurance (PQA) is a training program sanctioned by the National Pork Board that is required by most major meatpackers in the U.S. for pork producers supplying pigs to their operations. The Michigan Pork Producers Association and pork commodity organizations in all other major pork-producing states also sanction PQA; managers and animal care staff at all major pork operations are required to complete the training every three years.
As is the case for other major livestock care certification programs, PQA is accessed by most pork producers in the form of an online learning module followed by a written exam that must be completed by individual participants. While many U.S. pork producers have full access to online learning platforms and are happy to participate in online courses, many underserved audiences in agriculture do not have access to these platforms. In fact, some producers lack both access and authority to use any electronic technologies, as is the case for many of the Amish farmers residing in southern Michigan. Creating and delivering acceptable outreach using culturally appropriate technologies for this underserved audience is a current priority and focus of the MSU Extension pork team and other animal agriculture teams.
In October 2022, MSU Extension pork educators reached out to the owner-operator of a large swine production operation in Reading, Michigan, to explore the possibility of providing in-person PQA training to its partner small-holder pig farmers and their staff. These small-holder pig farms are located near the large producer’s farm. They typically finish growing 100 to 1,000 pigs each under contract with the large producer. Almost all the small-holder farmers are Amish and would not be able to complete the required PQA course if not provided access to in-person, lower-tech training. The large producer requested that MSU Extension provide local, in-person training using a large barn on his farm. The pork team modified the PQA curriculum for in-person delivery without weakening prescribed aspects of the training.
Attendees of the PQA course included 86 Amish farmers and staff who completed certification requirements, 16 family members and eight members of the main farm’s ownership and staff. Based on a discussion with the local church leader (deacon), the training provided was fully appropriate and respectful of attending members’ religious customs and beliefs. The farm leader was grateful and sent the team a card thanking them for conducting this on-farm training using a format that worked well for his small-holder Amish farmer partners.
"Thanks for making this training event in person and local on our own farm." -Tom Schadler, farmer
References
Michigan Department of Agriculture and Rural Development. (MDARD). (2023). Michigan Agriculture Facts and Figures. https://bit.ly/3X7MgHG
U.S. Department of Agriculture (USDA). (2024). Meat, poultry and egg product inspection directory. https://www.fsis.usda.gov/inspection/establishments/meat-poultry-and-egg-product-inspection-directory



 Print
Print Email
Email
